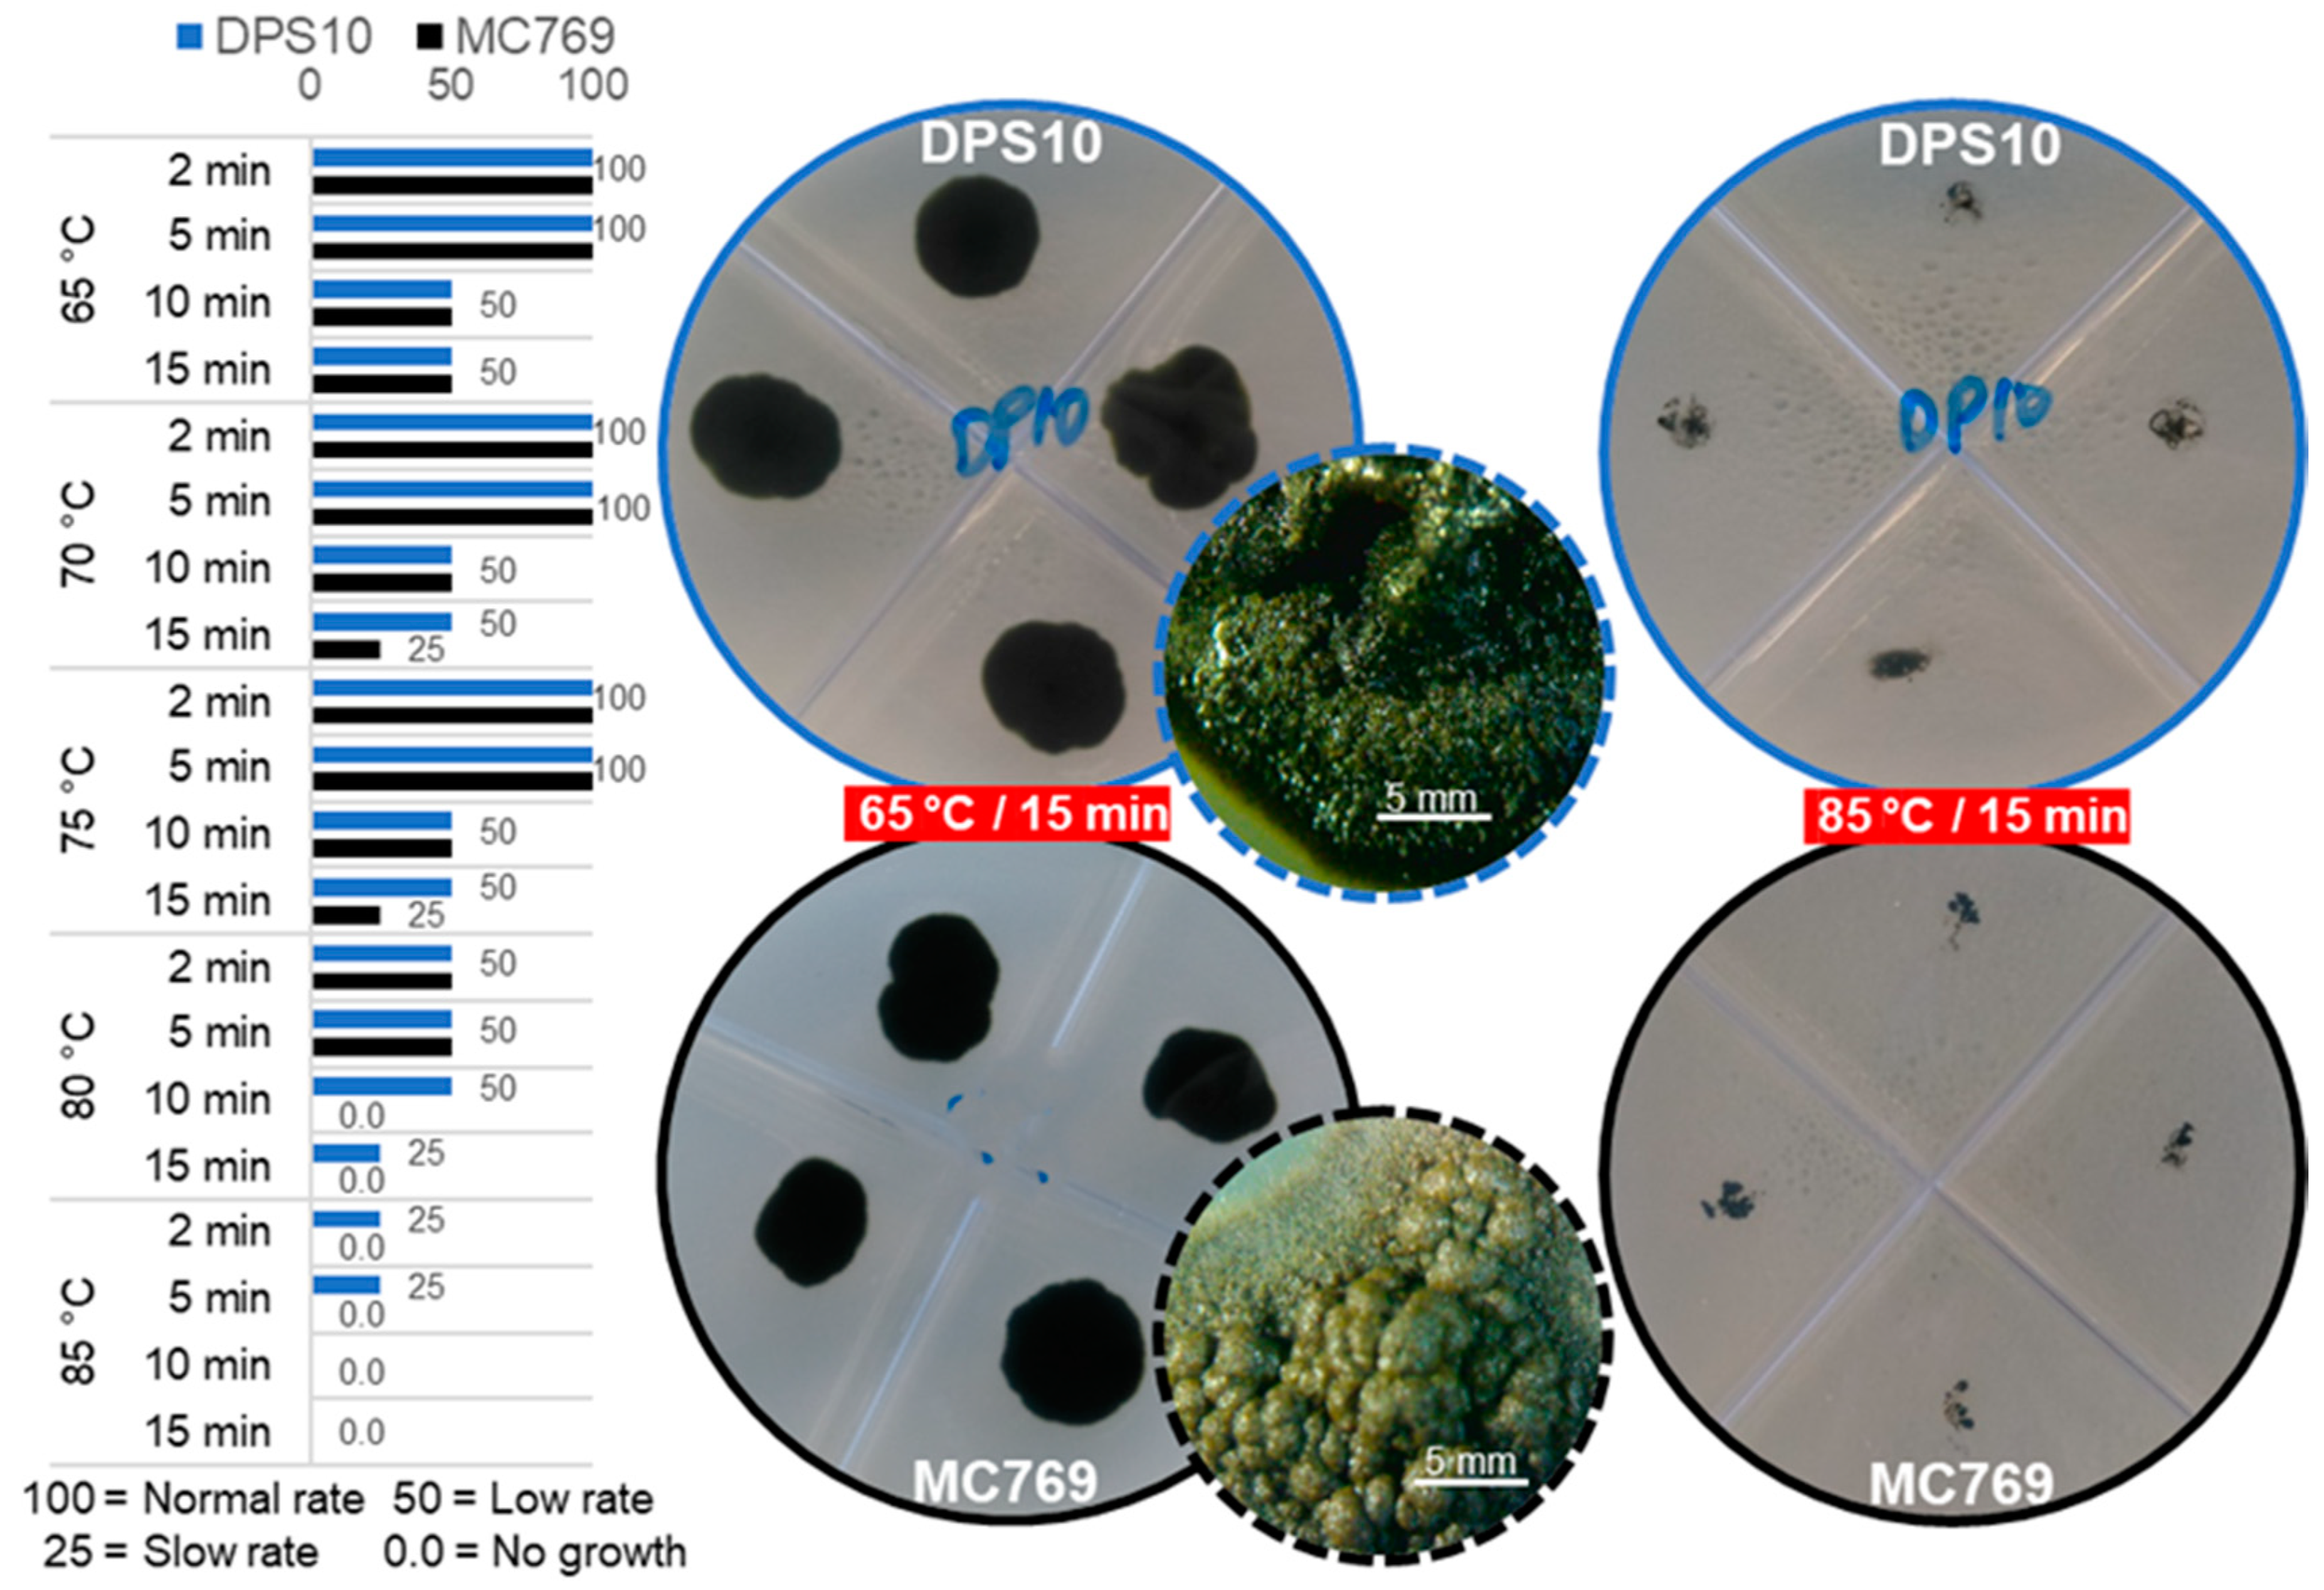
Jof 07 00104 g007 Jof 07 00104 g007

A New Extremotolerant Ecotype of the Fungus Pseudotaeniolina globosa Isolated from Djoser Pyramid, Memphis Necropolis, Egypt
Abstract
1. Introduction
2. Materials and Methods
2.1. Isolate Sampling
2.2. Morphological Characterization of Pseudotaeniolina Globosa
2.2.1. Hyphal Maturation and Conidiogenesis
2.2.2. Culture Media Preferences
2.3. Physiological Characterization of Pseudotaeniolina Globosa
2.3.1. Temperature Preferences
2.3.2. Growth at Different Salt Concentrations
2.3.3. Growth at Different pH
2.4. Tolerance Assessment of Pseudotaeniolina Globosa
2.4.1. UV Tolerance under Wet and Dry Conditions
2.4.2. Heat Stress Tolerance
2.5. Molecular Characterization of Pseudotaeniolina Globosa
2.5.1. DNA Extraction
2.5.2. Multi-Locus Genotyping
3. Results
3.1. Morphological Characterization of Pseudotaeniolina Globosa
3.1.1. Hyphal Maturation and Conidiogenesis
3.1.2. Culture Media Preferences
3.2. Physiological Characterization of Pseudotaeniolina Globosa
3.2.1. Temperature Preferences
3.2.2. Growth at Different NaCl Concentrations
3.2.3. Growth at Different pH
3.3. Tolerance Experiments of Pseudotaeniolina Globosa
3.3.1. UV Tolerance under Wet and Dry Conditions
3.3.2. Heat Stress Tolerance
3.4. Molecular Characterization and Phylogeny of Pseudotaeniolina Globosa
4. Discussion
Author Contributions
Funding
Institutional Review Board Statement
Informed Consent Statement
Data Availability Statement
Conflicts of Interest
References
- Staley, J.T.; Palmer, F.; Adams, J.B. Microcolonial fungi: Common inhabitants on desert rocks? Science 1982, 215, 1093–1095. [Google Scholar] [CrossRef] [PubMed]
- Wollenzien, U.; de Hoog, G.S.; Krumbein, W.E.; Urzí, C. On the isolation of microcolonial fungi occurring on and in marble and other calcareous rocks. Sci. Total Environ. 1995, 167, 287–294. [Google Scholar] [CrossRef]
- Ruibal, C.; Gueidan, C.; Selbmann, L.; Gorbushina, A.A.; Crous, P.W.; Groenewald, J.Z.; Muggia, L.; Grube, M.; Isola, D.; Schoch, C.L.; et al. Phylogeny of rock-inhabiting fungi related to Dothideomycetes. Stud. Mycol. 2009, 64, 123–133. [Google Scholar] [CrossRef] [PubMed]
- Sterflinger, K. Fungi as geologic agents. Geomicrobiol. J. 2000, 17, 97–124. [Google Scholar] [CrossRef]
- Gorbushina, A.A. Life on the rocks: Life on the rocks. Environ. Microbiol. 2007, 9, 1613–1631. [Google Scholar] [CrossRef] [PubMed]
- Selbmann, L.; de Hoog, G.S.; Mazzaglia, A.; Friedmann, E.I.; Onofri, S. Fungi at the edge of life: Cryptoendolithic black fungi from Antarctic desert. Stud. Mycol. 2005, 51, 1–32. [Google Scholar]
- Sterflinger, K. Black yeasts and meristematic fungi: Ecology, diversity and identification. In Biodiversity and Ecophysiology of Yeasts; Rosa, C.A., Péter, G., Eds.; Springer: Berlin/Heidelberg, Germany, 2006; pp. 501–514. [Google Scholar]
- Selbmann, L.; de Hoog, G.S.; Zucconi, L.; Isola, D.; Ruisi, S.; van den Ende, A.H.G.G.; Ruibal, C.; De Leo, F.; Urzì, C.; Onofri, S. Drought meets acid: Three new genera in a dothidealean clade of extremotolerant fungi. Stud. Mycol. 2008, 61, 1–20. [Google Scholar] [CrossRef]
- Sert, H.B.; Sterflinger, K. A new Coniosporium species from historical marble monuments. Mycol. Prog. 2010, 9, 353–359. [Google Scholar] [CrossRef]
- Sert, H.B.; Sümbül, H.; Sterflinger, K. Microcolonial fungi from antique marbles in Perge/Side/Termessos (Antalya/Turkey). Antonie Van Leeuwenhoek 2007, 91, 217–227. [Google Scholar] [CrossRef]
- Marvasi, M.; Donnarumma, F.; Frandi, A.; Mastromei, G.; Sterflinger, K.; Tiano, P.; Perito, B. Black microcolonial fungi as deteriogens of two famous marble statues in Florence, Italy. Int. Biodeterior. Biodegrad. 2012, 68, 36–44. [Google Scholar] [CrossRef]
- Isola, D.; Selbmann, L.; de Hoog, G.S.; Fenice, M.; Onofri, S.; Prenafeta-Boldú, F.X.; Zucconi, L. Isolation and screening of black fungi as degraders of volatile aromatic hydrocarbons. Mycopathologia 2013, 175, 369–379. [Google Scholar] [CrossRef] [PubMed]
- Isola, D.; Zucconi, L.; Onofri, S.; Caneva, G.; de Hoog, G.S.; Selbmann, L. Extremotolerant rock inhabiting black fungi from Italian monumental sites. Fungal Divers. 2016, 76, 75–96. [Google Scholar] [CrossRef]
- De Leo, F.; Urzì, C. Microfungi from deteriorated materials of cultural heritage. In Fungi from Different Substrates; Misra, J.K., Tewari, J.P., Deshmukh, S.K., Vágvölgyi, C., Eds.; CRC Press: Boca Ratón, FL, USA, 2015; pp. 144–158. [Google Scholar]
- Salvadori, O.; Municchia, A.C. The role of fungi and lichens in the biodeterioration of stone monuments. Open Conf. Proc. J. 2016, 7, 39–54. [Google Scholar] [CrossRef]
- De Leo, F.; Urzì, C.; de Hoog, G.S. A new meristematic fungus, Pseudotaeniolina globosa. Antonie Van Leeuwenhoek 2003, 83, 351–360. [Google Scholar] [CrossRef] [PubMed]
- Zucconi, L.; Gagliardi, M.; Isola, D.; Onofri, S.; Andaloro, M.C.; Pelosi, C.; Pogliani, P.; Selbmann, L. Biodeterioration agents dwelling in or on the wall paintings of the Holy Saviour’s cave (Vallerano, Italy). Int. Biodeterior. Biodegrad. 2012, 70, 40–46. [Google Scholar] [CrossRef]
- Onofri, S.; Zucconi, L.; Isola, D.; Selbmann, L. Rock-inhabiting fungi and their role in deterioration of stone monuments in the Mediterranean area. Plant Biosyst. 2014, 148, 384–391. [Google Scholar] [CrossRef]
- De Leo, F.; Antonelli, F.; Pietrini, A.M.; Ricci, S.; Urzì, C. Study of the euendolithic activity of blackmeristematic fungi isolated from a marble statue in the Quirinale Palace’s Gardens in Rome, Italy. Facies 2019, 65, 18. [Google Scholar] [CrossRef]
- De Leo, F.; Lo Giudice, A.; Alaimo, C.; De Carlo, G.; Rappazzo, A.C.; Graziano, M.; De Domenico, E.; Urzì, C. Occurrence of the black yeast Hortaea werneckii in the Mediterranean Sea. Extremophiles 2019, 23, 9–17. [Google Scholar] [CrossRef]
- Egidi, E.; de Hoog, G.S.; Isola, D.; Onofri, S.; Quaedvlieg, W.; de Vries, M.; Verkley, G.J.M.; Stielow, J.B.; Zucconi, L.; Selbmann, L. Phylogeny and taxonomy of meristematic rock-inhabiting black fungi in the Dothideomycetes based on multi-locus phylogenies. Fungal Divers. 2014, 65, 127–165. [Google Scholar] [CrossRef]
- Sterflinger, K.; de Hoog, G.S.; Haase, G. Phylogeny and ecology of meristematic ascomycetes. Stud. Mycol. 1999, 43, 5–22. [Google Scholar]
- Ruibal, C.; Platas, G.; Bills, G.F. Isolation and characterization of melanized fungi from limestone formations in Mallorca. Mycol. Prog. 2005, 4, 23–38. [Google Scholar] [CrossRef]
- Ruibal, C.; Platas, G.; Bills, G.F. High diversity and morphological convergence among melanised fungi from rock formations in the Central Mountain System of Spain. Pers. Mol. Phylogeny Evol. Fungi 2008, 21, 93–110. [Google Scholar] [CrossRef] [PubMed]
- Ruibal Villaseñor, C. Isolation and Characterization of Melanized, Slow-Growing Fungi from Semiarid Rock Surfaces of Central Spain and Mallorca. Ph.D. Thesis, Universidad Autónoma de Madrid, Madrid, Spain, 2004. [Google Scholar]
- Gueidan, C.; Savić, S.; Thüs, H.; Roux, C.; Keller, C.; Tibell, L.; Prieto, M.; Heiðmarsson, S.; Breuss, O.; Orange, A.; et al. Generic classification of the Verrucariaceae (Ascomycota) based on molecular and morphological evidence: Recent progress and remaining challenges. Taxon 2009, 58, 184–208. [Google Scholar] [CrossRef]
- Roskov, Y.; Ower, G.; Orrell, T.; Nicolson, D.; Bailly, N.; Kirk, P.M.; Bourgoin, T.; DeWalt, R.E.; Decock, W.; Nieukerken, E.V.; et al. Species 2000 & ITIS Catalogue of Life, 2019 Annual Checkist; Species 2000; Naturalis: Leiden, The Netherlands, 2020; Available online: www.catalogueoflife.org/annual-checklist/2019 (accessed on 10 October 2020).
- Afifi, H.; Geweely, N. Comparative study on fungal deterioration and ozone conservation of El-Anfoushi and Al-Shatby Archeological Tombs-Alexandria-Egypt. J. Am. Sci. 2011, 7, 776–784. [Google Scholar] [CrossRef]
- Mansour, M.; Ahmed, H. Occurrence of fungi on some deteriorated ancient Egyptian materials and their controlling by ecofriendly products. Egypt. J. Archaeol. Restor. Stud. 2012, 2, 91–101. [Google Scholar] [CrossRef]
- Mohamed, S.S.; Ibrahim, S.E. Characterization and management of fungal deterioration of ancient limestone at different sites along Egypt. Egypt. J. Microbiol. 2018, 53, 177–191. [Google Scholar] [CrossRef]
- Kane, J.; Summerbell, R.C. Sodium chloride as aid in identification of Phaeoannellomyces werneckii and other medically important dematiaceous fungi. J. Clin. Microbiol. 1987, 25, 944–946. [Google Scholar] [CrossRef]
- Küster, F.W.; Thiel, A. Tabelle per le Analisi Chimiche e Chimico-Fisiche, 14th ed.; HOEPLI: Milano, Italy, 1999. [Google Scholar]
- Möller, E.M.; Bahnweg, G.; Sandermann, H.; Geiger, H.H. A simple and efficient protocol for isolation of high molecular weight DNA from filamentous fungi, fruit bodies, and infected plant tissues. Nucleic Acids Res. 1992, 20, 6115–6116. [Google Scholar] [CrossRef]
- Urzì, C.; De Leo, F.; Lo Passo, C.; Criseo, G. Intra-specific diversity of Aureobasidium pullulans strains isolated from rocks and other habitats assessed by physiological methods and by random amplified polymorphic DNA (RAPD). J. Microbiol. Methods 1999, 36, 95–105. [Google Scholar] [CrossRef]
- Kearse, M.; Moir, R.; Wilson, A.; Stones-Havas, S.; Cheung, M.; Sturrock, S.; Buxton, S.; Cooper, A.; Markowitz, S.; Duran, C.; et al. Geneious basic: An integrated and extendable desktop software platform for the organization and analysis of sequence data. Bioinformatics 2012, 28, 1647–1649. [Google Scholar] [CrossRef]
- Thompson, J.D.; Higgins, D.G.; Gibson, T.J. CLUSTAL W: Improving the sensitivity of progressive multiple sequence alignment through sequence weighting, position-specific gap penalties and weight matrix choice. Nucleic Acids Res. 1994, 22, 4673–4680. [Google Scholar] [CrossRef] [PubMed]
- Price, M.N.; Dehal, P.S.; Arkin, A.P. FastTree 2—Approximately maximum-likelihood trees for large alignments. PLoS ONE 2010, 5, e9490. [Google Scholar] [CrossRef] [PubMed]
- White, T.J.; Bruns, T.; Lee, S.; Taylor, J.W. Amplification and direct sequencing of fungal ribosomal RNA genes for phylogenetics. In PCR Protocols: A Guide to Methods and Applications; Innis, M.A., Gelfand, D.H., Sninsky, J.J., White, T.J., Eds.; Academic Press: New York, NY, USA, 1990; pp. 315–322. [Google Scholar]
- Crous, P.W.; Schoch, C.L.; Hyde, K.D.; Wood, A.R.; Gueidan, C.; de Hoog, G.S.; Groenewald, J.Z. Phylogenetic lineages in the Capnodiales. Stud. Mycol. 2009, 64, 17–47. [Google Scholar] [CrossRef] [PubMed]
- Vilgalys, R.; Hester, M. Rapid genetic identification and mapping of enzymatically amplified ribosomal DNA from several Cryptococcus species. J. Bacteriol. 1990, 172, 4238–4246. [Google Scholar] [CrossRef] [PubMed]
- O’Donnell, K.; Cigelnik, E. Two divergent intragenomic rDNA ITS2 types within a monophyletic lineage of the fungus Fusarium are nonorthologous. Mol. Phylogenet. Evol. 1997, 7, 103–116. [Google Scholar] [CrossRef] [PubMed]
- Liu, Y.J.; Whelen, S.; Hall, B.D. Phylogenetic relationships among ascomycetes: Evidence from an RNA polymerse II subunit. Mol. Biol. Evol. 1999, 16, 1799–1808. [Google Scholar] [CrossRef]
- Quaedvlieg, W.; Kema, G.H.J.; Groenewald, J.Z.; Verkley, G.J.M.; Seifbarghi, S.; Razavi, M.; Gohari, A.M.; Mehrabi, R.; Crous, P.W. Zymoseptoria gen. nov.: A new genus to accommodate Septoria-like species occurring on Graminicolous hosts. Pers. Mol. Phylogeny Evol. Fungi 2011, 26, 57–69. [Google Scholar] [CrossRef]
- de Hoog, S.; Zalar, P.; Urzì, C.; De Leo, F.; Yurlova, N.; Sterflinger, K. Relationships of dothideaceous black yeasts and meristematic fungi based on 5.8S and ITS2 rDNA sequence comparison. Stud. Mycol. 1999, 43, 31–37. [Google Scholar]
- Kurzai, O.; Keith, P.; Hoog, S.; Abele-Horn, M.; Frosch, M. Postmortem isolation of Pseudotaeniolina globosa from a patient with aortic aneurysm. Mycoses 2003, 46, 141–144. [Google Scholar] [CrossRef]
- Gorfer, M.; Blumhoff, M.; Klaubauf, S.; Urban, A.; Inselsbacher, E.; Bandian, D.; Mitter, B.; Sessitsch, A.; Wanek, W.; Strauss, J. Community profiling and gene expression of fungal assimilatory nitrate reductases in agricultural soil. ISME J. 2011, 5, 1771–1783. [Google Scholar] [CrossRef]
- Gorfer, M.; Klaubauf, S.; Berger, H.; Strauss, J. The fungal contribution to the nitrogen cycle in agricultural soils. In Metagenomics of the Microbial Nitrogen Cycle: Theory, Methods and Applications; Marco, D., Ed.; Caister Academic Press: Córdoba, Argentina, 2014; pp. 209–225. [Google Scholar]
- Ortiz, R.; Navarrete, H.; Navarrete, J.; Párraga, M.; Carrasco, I.; de la Vega, E.; Ortiz, M.; Herrera, P.; Blanchette, R.A. Deterioration, decay and identification of fungi isolated from wooden structures at the Humberstone and Santa Laura saltpeter works: A world heritage site in Chile. Int. Biodeterior. Biodegrad. 2014, 86, 309–316. [Google Scholar] [CrossRef]
- Piñar, G.; Dalnodar, D.; Voitl, C.; Reschreiter, H.; Sterflinger, K. Biodeterioration risk threatens the 3100 year old staircase of Hallstatt (Austria): Possible involvement of halophilic microorganisms. PLoS ONE 2016, 11, e0148279. [Google Scholar] [CrossRef] [PubMed]
- Perez, C.; Colella, M.T.; Olaizola, C.; de Capriles, C.H.; Magaldi, S.; Mata-Essayag, S. Tinea Nigra: Report of twelve cases in Venezuela. Mycopathologia 2005, 160, 235–238. [Google Scholar] [CrossRef] [PubMed]
- Urzì, C.; De Leo, F.; De Hoog, S.; Sterflinger, K. Recent advances in the molecular biology and ecophysiology of meristematic stone-inhabiting fungi. In Of Microbes and Art: The role of Microbial Communities in the Degradation and Protection of Cultural Heritage; Ciferri, O., Tiano, P., Mastromei, G., Eds.; Springer: Boston, MA, USA, 2000; pp. 3–19. [Google Scholar]
- Gorbushina, A. Microcolonial fungi: Survival potential of terrestrial vegetative structures. Astrobiology 2003, 3, 543–554. [Google Scholar] [CrossRef]
- Ametrano, C.G.; Muggia, L.; Grube, M. Extremotolerant black fungi from rocks and lichens. In Fungi in Extreme Environments: Ecological Role and Biotechnological Significance; Tiquia-Arashiro, S.M., Grube, M., Eds.; Springer: Cham, Switzerland, 2019; pp. 119–143. [Google Scholar]
- Urzì, C.; Wollenzien, U.; Criseo, G.; Krumbein, W.E. Biodiversity of the rock inhabiting microflora with special reference to black fungi and black yeasts. Microb. Divers. Ecosyst. Funct. 1995, 16, 289–302. [Google Scholar]
- Wollenzien, U.; de Hoog, G.S.; Krumbein, W.; Uijthof, J.M.J. Sarcinomyces petricola, a new microcolonial fungus from marble in the Mediterranean basin. Antonie Van Leeuwenhoek 1997, 71, 281–288. [Google Scholar] [CrossRef]
- Tsuneda, A.; Hambleton, S.; Currah, R.S. The Anamorph Genus Knufia and its phylogenetically allied species in Coniosporium, Sarcinomyces, and Phaeococcomyces. Botany 2011, 89, 523–536. [Google Scholar] [CrossRef]
- Kaštovská, K.; Elster, J.; Stibal, M.; Šantrůčková, H. Microbial assemblages in soil microbial succession after glacial retreat in Svalbard (High Arctic). Microb. Ecol. 2005, 50, 396. [Google Scholar] [CrossRef]
- Gunde-Cimerman, N.; Ramos, J.; Plemenitaš, A. Halotolerant and halophilic fungi. Mycol. Res. 2009, 113, 1231–1241. [Google Scholar] [CrossRef]
- Prista, C.; Loureiro-Dias, M.C.; Montiel, V.; García, R.; Ramos, J. Mechanisms underlying the halotolerant way of Debaryomyces hansenii. FEMS Yeast Res. 2005, 5, 693–701. [Google Scholar] [CrossRef]
- Plemenitaš, A.; Vaupotič, T.; Lenassi, M.; Kogej, T.; Gunde-Cimerman, N. Adaptation of extremely halotolerant black yeast Hortaea werneckii to increased osmolarity: A molecular perspective at a glance. Stud. Mycol. 2008, 61, 67–75. [Google Scholar] [CrossRef] [PubMed]
- Zalar, P.; Sybren de Hoog, G.; Schroers, H.-J.; Frank, J.M.; Gunde-Cimerman, N. Taxonomy and phylogeny of the xerophilic genus Wallemia (Wallemiomycetes and Wallemiales, cl. et ord. nov.). Antonie Van Leeuwenhoek 2005, 87, 311–328. [Google Scholar] [CrossRef] [PubMed]
- Pitt, J.I.; Hocking, A.D. Fungi and Food Spoilage, 3rd ed.; Springer: Dordrecht, The Netherlands, 2009; p. 519. [Google Scholar]
- Grishkan, I. Ecological stress: Melanization as a response in fungi to radiation. In Extremophiles Handbook; Horikoshi, K., Ed.; Springer: Tokyo, Japan, 2011; pp. 1135–1145. [Google Scholar]

| Locus | Primer (Direction) | Annealing (°C) | Reference |
|---|---|---|---|
| ITS | ITS1 (F) | 50 | [38] |
| ITS4 (R) | |||
| nrSSU | NS1 (F) | 55 | [38] |
| NS3 (F) | |||
| NS5 (F) | |||
| NS7 (F) | |||
| NS24 (R) | |||
| nrLSU | LSU1Fd (F) | 52 | [39] |
| LR5 (R) | [40] | ||
| BT2 | T1 | 52 | [41] |
| T22 | |||
| RPB2 | fRPB2-5F | 49 | [42] |
| fRPB2-5F+414R | [43] |
| Isolate Code | Isolation Country | GenBank Accession Number | References | ||||
|---|---|---|---|---|---|---|---|
| ITS | nrSSU (18S) | nrLSU (28S) | BT2 | RPB2 | |||
| CBS 303.84 * | Germany | AJ244268 | - | - | - | - | [44] |
| CBS 110353 | Germany | AJ244268 ** | - | - | - | - | [45] |
| MC769 *** | Italy | AY128700 | NG062782 | MW367900 | MW371112 | MW371115 | [16], current study |
| L10 | Austria | HQ115663 | - | - | - | - | [46] |
| ICP 1002 | Austria | KC311489 | - | - | - | - | [47] |
| CCFEE 5734 | Italy | KF309976 | - | KF310010 | KF546758 | KF310073 | [21] |
| H19 | Chili | KF578436 | - | - | - | [48] | |
| HF24 | Austria | KR081416 | - | - | - | - | [49] |
| DPS10 | Egypt | MH396690 | MH396869 | MH396691 | MW371113 | MW371114 | Current study |
Publisher’s Note: MDPI stays neutral with regard to jurisdictional claims in published maps and institutional affiliations. |
© 2021 by the authors. Licensee MDPI, Basel, Switzerland. This article is an open access article distributed under the terms and conditions of the Creative Commons Attribution (CC BY) license (http://creativecommons.org/licenses/by/4.0/).
Share and Cite
Rizk, S.M.; Magdy, M.; De Leo, F.; Werner, O.; Rashed, M.A.-S.; Ros, R.M.; Urzì, C. A New Extremotolerant Ecotype of the Fungus Pseudotaeniolina globosa Isolated from Djoser Pyramid, Memphis Necropolis, Egypt. J. Fungi 2021, 7, 104. https://doi.org/10.3390/jof7020104
Rizk SM, Magdy M, De Leo F, Werner O, Rashed MA-S, Ros RM, Urzì C. A New Extremotolerant Ecotype of the Fungus Pseudotaeniolina globosa Isolated from Djoser Pyramid, Memphis Necropolis, Egypt. Journal of Fungi. 2021; 7(2):104. https://doi.org/10.3390/jof7020104
Chicago/Turabian StyleRizk, Samah Mohamed, Mahmoud Magdy, Filomena De Leo, Olaf Werner, Mohamed Abdel-Salam Rashed, Rosa Maria Ros, and Clara Urzì. 2021. "A New Extremotolerant Ecotype of the Fungus Pseudotaeniolina globosa Isolated from Djoser Pyramid, Memphis Necropolis, Egypt" Journal of Fungi 7, no. 2: 104. https://doi.org/10.3390/jof7020104
APA StyleRizk, S. M., Magdy, M., De Leo, F., Werner, O., Rashed, M. A.-S., Ros, R. M., & Urzì, C. (2021). A New Extremotolerant Ecotype of the Fungus Pseudotaeniolina globosa Isolated from Djoser Pyramid, Memphis Necropolis, Egypt. Journal of Fungi, 7(2), 104. https://doi.org/10.3390/jof7020104

